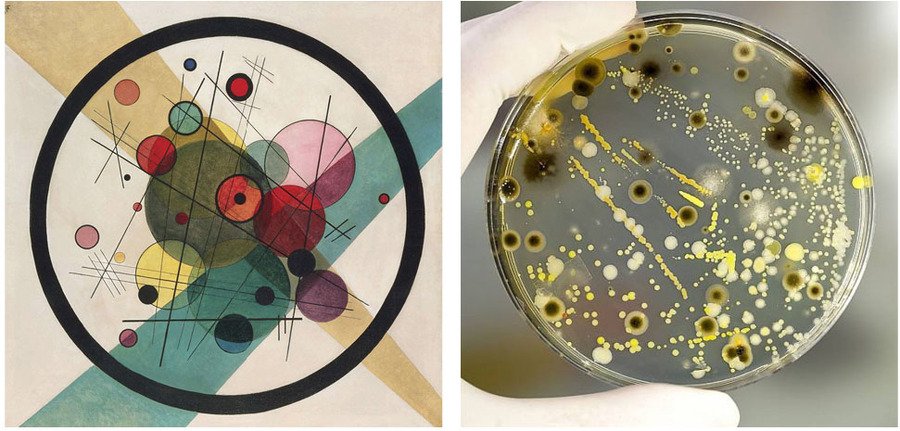
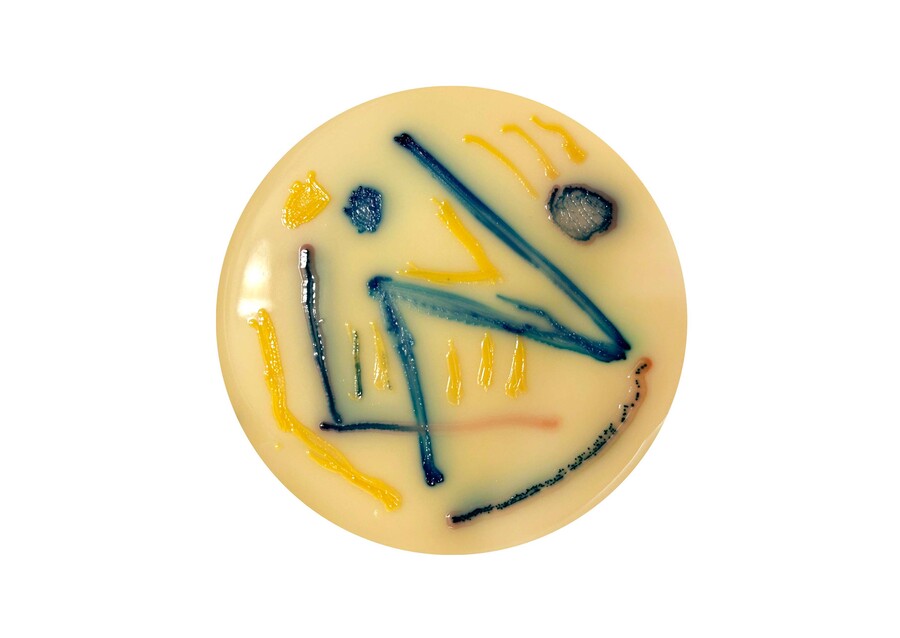
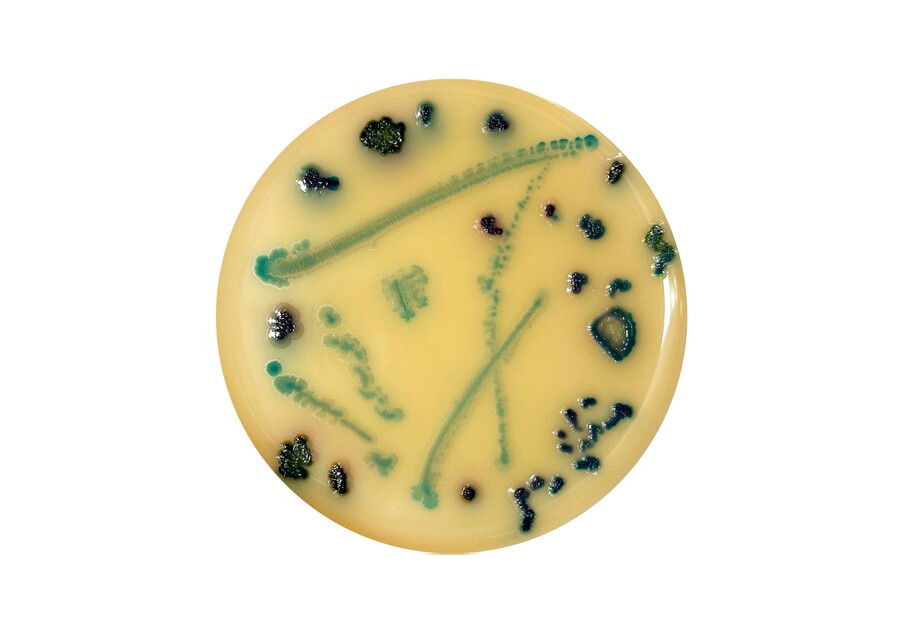

Лаборатория абстракционизма
Концепция
«Бытующее до сего дня утверждение, что „разлагать“ искусство опасно, поскольку это „разложение“ неизбежно приведет к смерти искусства, происходит из незнания, занижающего ценность освобожденных элементов и их первородной силы».
Василий Кандинский «Точка и линия на плоскости»
Василий Кандинский «Круги в круге» / Чашка Петри
Процесс работы
Мысль Кандинского о том, что искусство можно «разлагать», так как она даст ему новую жизнь, натолкнула меня на включение в проект естественно-научной составляющей. Я решила вырастить в чашках Петри бактерии определенных форм, цветов и видов, которые напоминают абстрактные полотна Кандинского не только визуально, но и концептуально: как простые, но наполненные жизнью и движением элементы.

Выращивание чашек Петри в лаборатории
Полученные рисунки из выращенных бактерий
Готовый арт-объект
При создании арт-объекта я анимировала получившиеся рисунки в чашке Петри чтобы усилить ощущение «живой картины».